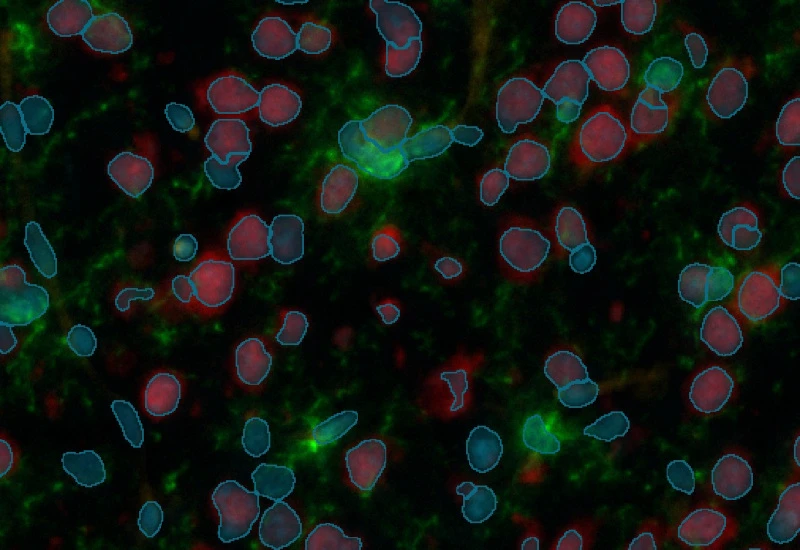

IF Neuronal Cells
Detect neuronal cells and reconstruct neurites/dendrites, quantify primary and secondary branches, branching points, total cell area, branch length, and branch area.
single-cell analysis
neuroscience
neuronal cells, microglia, central nervous system, peripheral nervous system, phagocytosis, astrocytes, branches, fluorescence

The IF Neuronal App identifies neuronal cells and their branches. It quantifies the number of neurites/dendrites branching out from a specific neuronal cell, identifies branching points, and exports total cell area, total branch length, and the number of branch points.

Original Image
Nuclei detection

Astrocyte identification

Branches and branching points
neuroscience

White Paper
30 Mar, 2026
Understanding NeuroCOVID-19: SARS-CoV-2 Disrupts Astrocyte Homeostatic Functions
single-cell analysis

White Paper
30 Mar, 2026
Understanding NeuroCOVID-19: SARS-CoV-2 Disrupts Astrocyte Homeostatic Functions
We support the following file formats:
- TissueFAXS (aqproj)
- StrataFAXS II (vmic)
- PreciPoint (vmic, gtif)
- Generic BigTIFF Import
- Support for multipage BigTIFF files
- OME-TIFF
- JPEG, PNG, BMP, TIFF
- Zeiss (czi)
- Hamamatsu NanoZoomer (ndpi)
- Aperio (svs)
- Leica (scn)
- 3D HISTECH Pannoramic
- Mirax (mrxs)
- Olympus (vsi)
- More slide scanners to be added!
Related Apps

IHC Microglia
Detect microglia soma in IHC-stained samples, segment branches, and identify primary and secondary branching points to quantify cell morphology and branching complexity.
microglia, central nervous system, peripheral nervous system, phagocytosis, astrocytes, branches

Custom App development
Perfectly tailored image analysis solutions for your research.
You have a specific research question that needs to be answered? We offer custom development of image analysis pipelines for specific tasks, be it detection of cellular phenotypes or quantification of tissue structures. After discussing your goals with one of our experts, you will get a ready-to-use App and be a step closer to an impactful publication.



